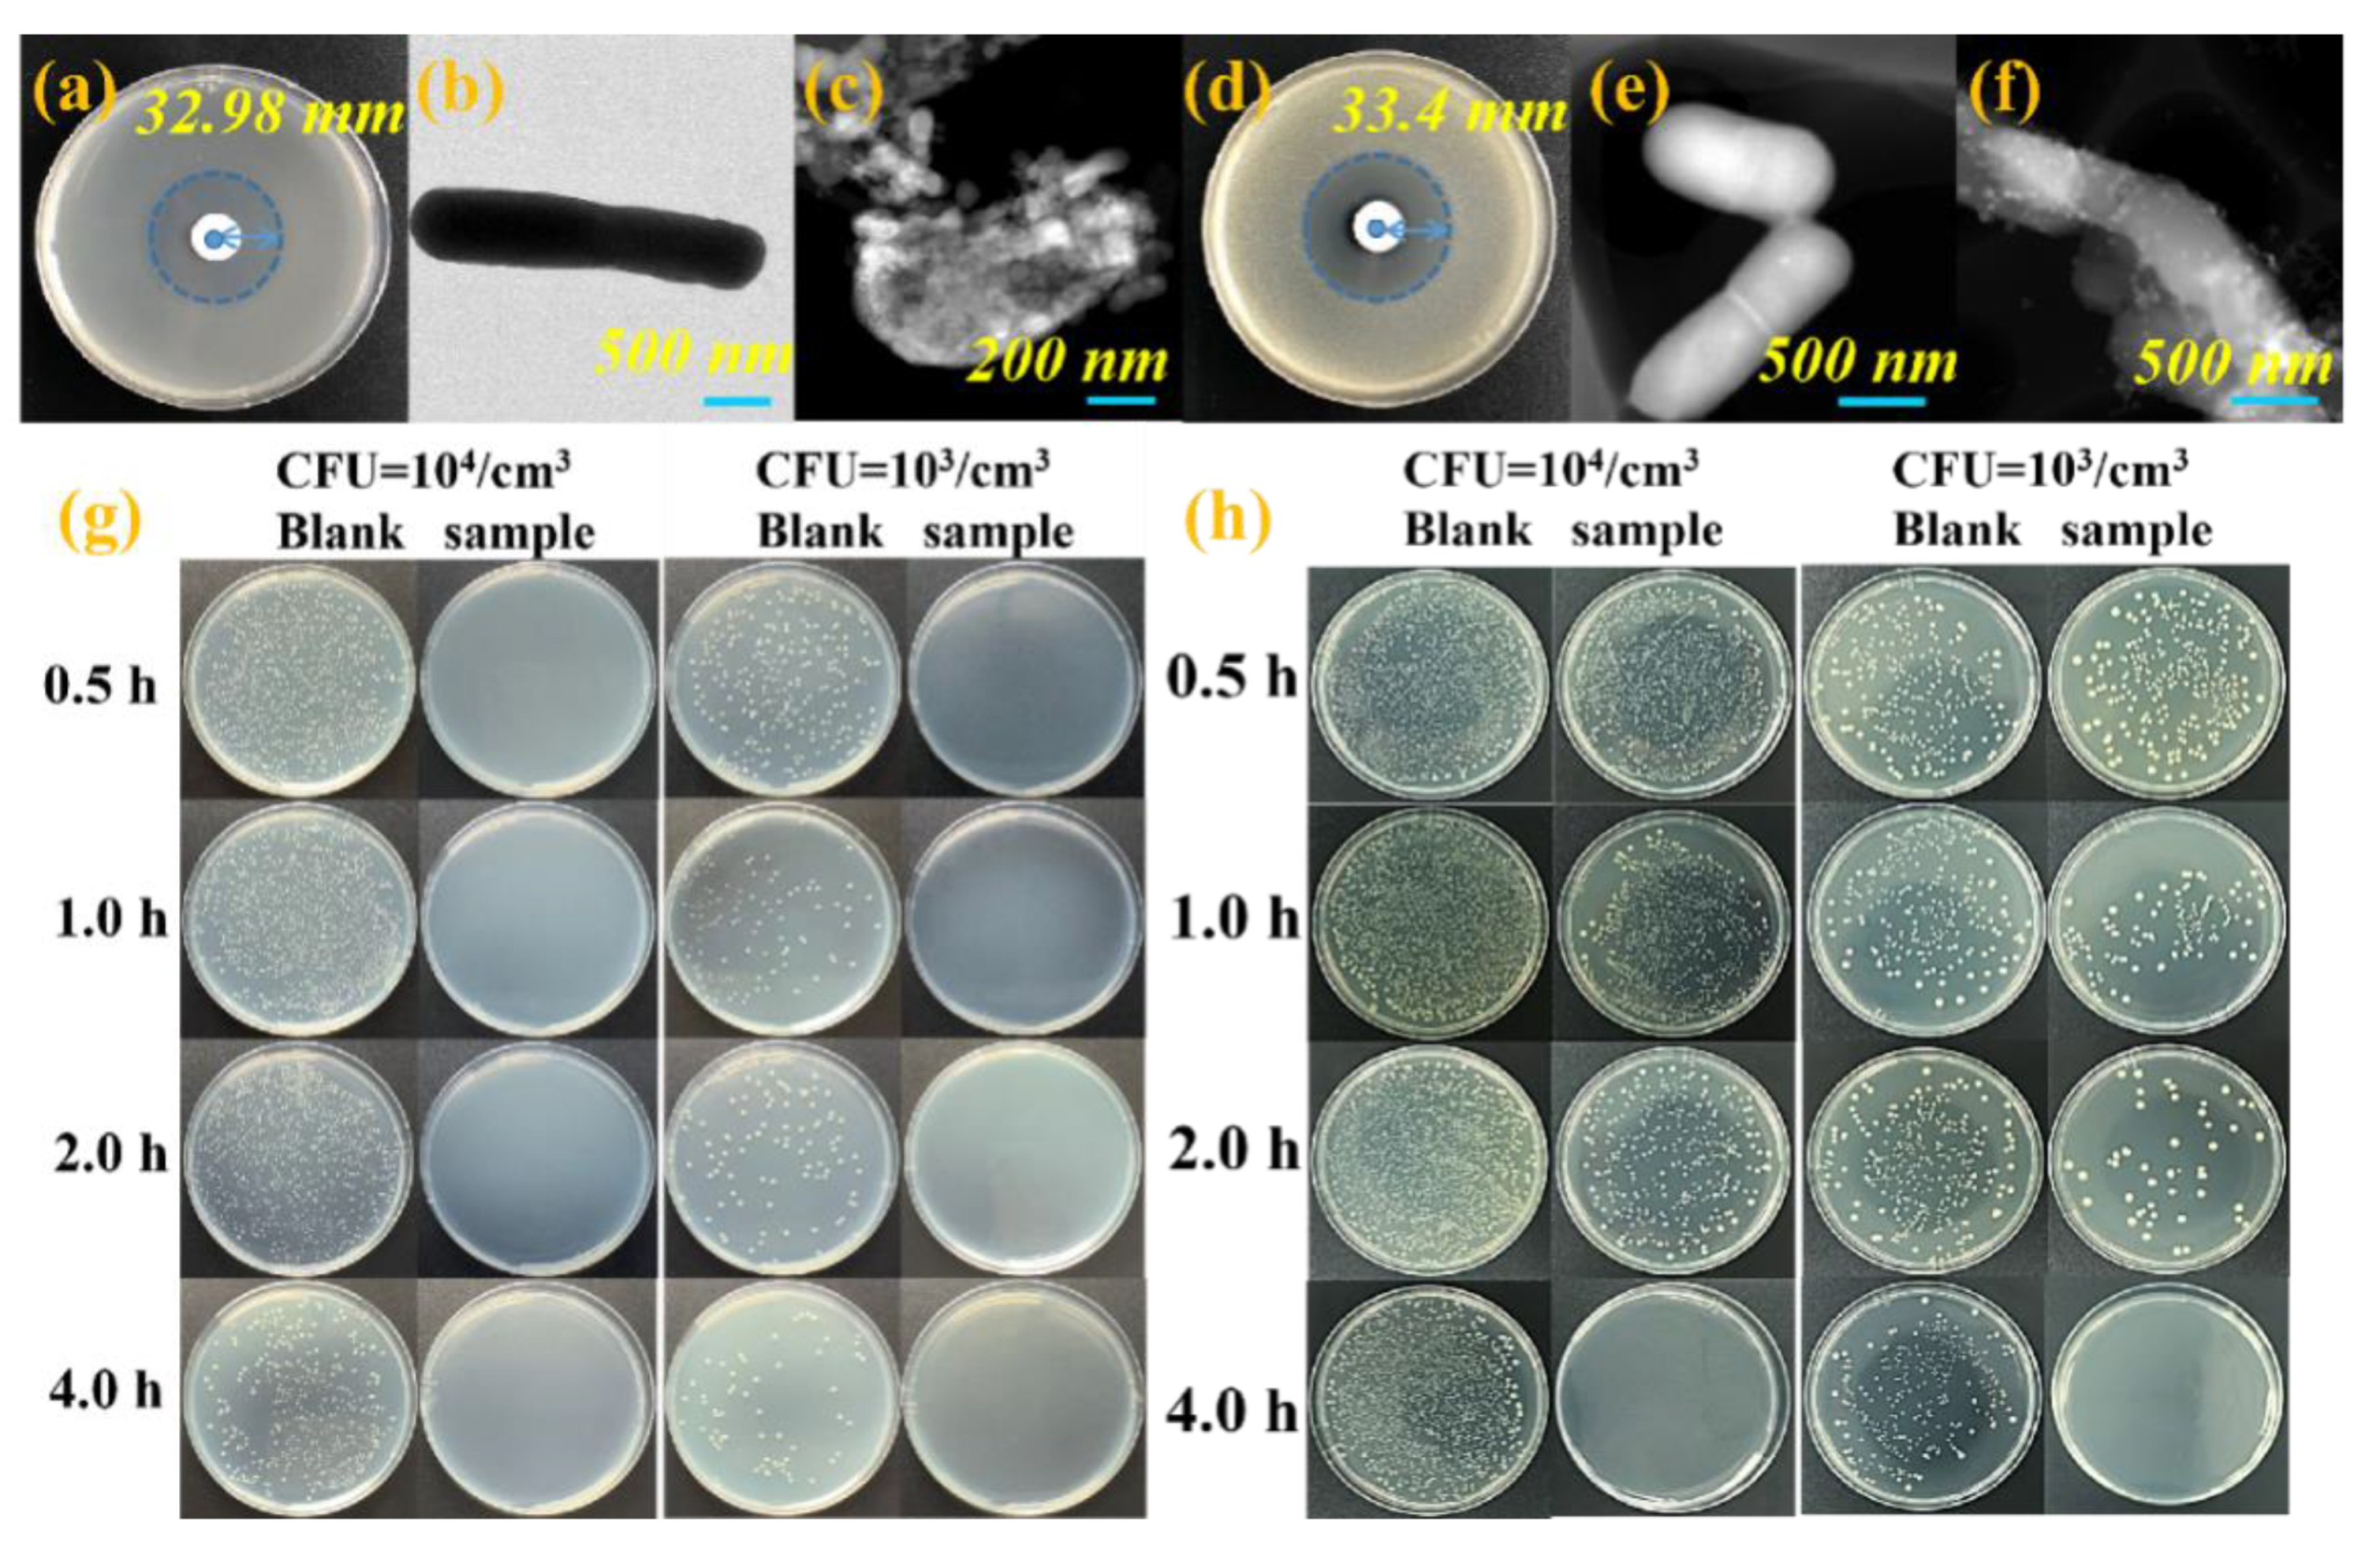
Nanomaterials 13 00202 g002 Nanomaterials 13 00202 g002

Preparation of 2D ZIF-L and Its Antibacterial and Antifouling Properties
Abstract
1. Introduction
2. Materials and Methods
2.1. Materials
2.2. Synthesis of ZIF-L
2.3. Preparation of ZIF-L/Epoxy Composites
2.4. Materials Characterizations
2.5. Antibacterial Property Test of ZIF-L
2.6. Bacteria and Algae Anti-Adhesion Assessment of ZIF-L/Epoxy Composites
3. Results and Discussion
3.1. Morphology and Structural Evolution of ZIF-L
3.2. Antibacterial Activity Evaluation
3.3. Exploring the Bactericidal Mechanism of ZIF-L
3.4. Antibacterial Effect of ZIF-L/Epoxy Composites
3.5. Algae Resistance of ZIF-L/Epoxy Composites
4. Conclusions
Supplementary Materials
Author Contributions
Funding
Data Availability Statement
Conflicts of Interest
References
- Li, J.; Li, J.; Wei, J.; Zhu, X.; Qiu, S.; Zhao, H. Copper Tannic Acid-Coordinated Metal–Organic Nanosheets for Synergistic Antimicrobial and Antifouling Coatings. ACS Appl. Mater. Interfaces 2021, 13, 10446–10456. [Google Scholar] [CrossRef] [PubMed]
- Koschitzki, F.; Wanka, R.; Sobota, L.; Gardner, H.; Hunsucker, K.; Swain, G.; Rosenhahn, A. Amphiphilic Zwitterionic Acrylate/Methacrylate Copolymers for Marine Fouling-Release Coatings. Langmuir. ACS J. Surf. Colloid. 2021, 37, 5591–5600. [Google Scholar] [CrossRef] [PubMed]
- Yang, H.; Guo, X.; Chen, R.; Liu, Q.; Zhang, M. Enhanced anti-biofouling ability of polyurethane anti-cavitation coating with ZIF-8: A comparative study of various sizes of ZIF-8 on coating. Eur. Polym. J. 2021, 144, 110212. [Google Scholar] [CrossRef]
- Shanmuganathan, R.; Sathishkumar, G.; Brindhadevi, K.; Pugazhendhi, A. Fabrication of naringenin functionalized-Ag/RGO nanocomposites for potential bactericidal effects. J. Mater. Res. Technol. 2020, 9, 7013–7019. [Google Scholar] [CrossRef]
- Jiang, S.; Sreethawong, T.; Lee, S.S.C.; Low, M.B.J.; Win, K.Y.; Brzozowska, A.M.; Teo, S.L.-M.; Vancso, G.J.; Jańczewski, D.; Han, M.-Y. Fabrication of Copper Nanowire Films and their Incorporation into Polymer Matrices for Antibacterial and Marine Antifouling Applications. Adv. Mater. Interfaces 2015, 2, 1400483. [Google Scholar] [CrossRef]
- Srinivasan, M.; Swain, G.W. Managing the use of copper-based antifouling paints. Environ. Manag. 2007, 39, 423–441. [Google Scholar] [CrossRef]
- Kiil, S.; Dam-Johansen, K. Characterization of pigment-leached antifouling coatings using BET surface area measurements and mercury porosimetry. Prog. Org. Coat. 2007, 60, 238–247. [Google Scholar] [CrossRef]
- Szeto, W.; Leung, M.K.H.; Leung, D.Y.C. Recent developments of titanium dioxide materials for aquatic antifouling application. J. Mater. Res. Technol. 2020, 26, 301–321. [Google Scholar] [CrossRef]
- Sree, G.S.; Mohan, B.S.; Reddy, B.J.M.; Ranjitha, K.V.B. Deterioration of Cadmium and pathogens from contaminated water using hydrothermally prepared NiO-ZnO-RGO composite. J. Mater. Res. Technol. 2021, 10, 976–987. [Google Scholar] [CrossRef]
- Li, M.; Tang, X.N.; Gao, X.; Zhang, H.; Cai, S.B.; Shan, S.Y. Nano ZnO-decorated corn stalk for three-dimensional composite filter with efficiently antimicrobial action. J. Mater. Res. Technol. 2021, 12, 444–454. [Google Scholar] [CrossRef]
- Chapman, J.; Nor, L.L.; Brown, R.; Kitteringham, E.; Russell, S.; Sullivan, T.; Regan, F. Antifouling performances of macro-to micro-to nano-copper materials for the inhibition of biofouling in its early stages. J. Mater. Chem. B 2013, 1, 6194–6200. [Google Scholar] [CrossRef] [PubMed]
- Purcell-Milton, F.; Mckenna, R.; Brennan, L.J.; Cullen, C.P.; Gun’Ko, Y.K. Induction of chirality in Two-Dimensional nanomaterials: Chiral 2D MoS2 nanostructures. Acs Nano 2018, 12, 954. [Google Scholar] [CrossRef]
- Sun, H.; Ang, H.M.; Tadé, M. Adsorptive remediation of environmental pollutants using novel graphene-based nanomaterials. Chem. Eng. J. 2013, 226, 336. [Google Scholar] [CrossRef]
- D’Urso, L.; Forte, G.; Russo, P.; Caccamo, C.; Compagnini, G.; Puglisi, O. Surface-enhanced Raman Scattering Study on 1D-2D Graphene-based Structures. Carbon 2011, 49, 3149–3157. [Google Scholar] [CrossRef]
- Wang, Y.; Wang, P.D.X.; Antonietti, P.D.M. Polymeric Graphitic Carbon Nitride as a Heterogeneous Organocatalyst: From Photochemistry to Multipurpose Catalysis to Sustainable Chemistry. Angew. Chem. Int. Edit. 2012, 51, 68–89. [Google Scholar] [CrossRef] [PubMed]
- Wang, X.; Blechert, S.; Antonietti, M. Polymeric Graphitic Carbon Nitride for Heterogeneous Photocatalysis. Acs Catal. 2012, 2, 1596–1606. [Google Scholar] [CrossRef]
- Khan, M.Q.; Kharaghani, D.; Nishat, N.; Shahzad, A.; Hussain, T.; Khatri, Z.; Zhu, C.H.; Kim, I.S. Preparation and characterizations of multifunctional PVA/ZnO nanofibers composite membranes for surgical gown application. J. Mater. Res. Technol. 2019, 8, 1328–1334. [Google Scholar] [CrossRef]
- Poizot, P.; Laruelle, S.; Grugeon, S.; Dupont, L.; Tarascon, J.-M. Nano-sized transition-metal oxides as negative-electrode materials for lithium-ion batteries. Nature 2000, 407, 496–499. [Google Scholar] [CrossRef]
- Ayari, A.; Cobas, E.; Ogundadegbe, O.; Fuhrer, M.S. Realization and electrical characterization of ultrathin crystals of layered transition-metal dichalcogenides. J. Appl. Phys. 2007, 101, 014507. [Google Scholar] [CrossRef]
- Goh, K.H.; Lim, T.T.; Dong, Z. Application of layered double hydroxides for removal of oxyanions: A review. Water Res. 2008, 42, 1343–1368. [Google Scholar] [CrossRef]
- Xu, Z.; Wu, T.; Shi, J.; Teng, K.; Wang, W.; Ma, M.; Li, J.; Qian, X.; Li, C.; Fan, J. Photocatalytic antifouling PVDF ultrafiltration membranes based on synergy of graphene oxide and TiO2 for water treatment. J. Membr. Sci. 2016, 520, 281–293. [Google Scholar] [CrossRef]
- Maxine, S.; Li, Y.; Khiew, P.S.; Chiu, W.S.; Tan, Y.F.; Kok, Y.; Leong, C.O. Green synthesis of graphene-silver nanocomposites and its application as a potent marine antifouling agent. Colloids Surf. B 2016, 148, 392–401. [Google Scholar] [CrossRef]
- Sun, Z.; Gu, L.; Zheng, J.; Zhang, J.; Wang, L.; Xu, F.; Lin, C. A controlled release strategy of antifouling agent in coating based on intercalated layered double hydroxides. Mater. Lett. 2016, 172, 105–108. [Google Scholar] [CrossRef]
- Qiu, T.; Liang, Z.; Guo, W.; Tabassum, H.; Zou, R. Metal-Organic Framework-Based Materials for Energy Conversion and Storage. ACS Energy Lett. 2020, 5, 520–532. [Google Scholar] [CrossRef]
- Chen, R.; Yao, J.; Gu, Q.; Smeets, S.; Baerlocher, C.; Gu, H.; Zhu, D.; Morris, W.; Yaghi, O.M.; Wang, H. A two-dimensional zeolitic imidazolate framework with a cushion-shaped cavity for CO2 adsorption. Chem. Commun. 2013, 49, 9500–9502. [Google Scholar] [CrossRef] [PubMed]
- Ding, B.; Wang, X.; Xu, Y.; Feng, S.; Ding, Y.; Xu, W.; Wang, H. Hydrothermal preparation of hierarchical ZIF-L nanostructures for enhanced CO2 capture. J. Colloid. Interf. Sci. 2018, 519, 38–43. [Google Scholar] [CrossRef] [PubMed]
- Xia, W.; Tang, J.; Li, J.; Zhang, S.; Wu, K.; He, J.; Yamauchi, Y. Defect-Rich Graphene Nanomesh Produced by Thermal Exfoliation of Metal-Organic Frameworks for the Oxygen Reduction Reaction. Angew. Chem. Int. 2019, 58, 13354–13359. [Google Scholar] [CrossRef] [PubMed]
- Xu, B.; Wang, H.; Wang, W.; Gao, L.; Li, S.; Pan, X.; Wang, H.; Yang, H.; Meng, X.; Wu, Q. Single-Atom Nanozyme for Wound Antibacterial Applications. Angew. Chem. Int. 2019, 58, 4911–4916. [Google Scholar] [CrossRef]
- Li, P.; Li, J.; Feng, X.; Li, J.; Wang, B. Metal-organic frameworks with photocatalytic bactericidal activity for integrated air cleaning. Nat. Commun. 2019, 2177, 1. [Google Scholar] [CrossRef]
- Halim, N.S.A.; Wirzal, M.D.H.; Bilad, M.R.; Nordin, N.A.H.M.; Putra, Z.A.; Yusoff, A.R.M.; Narkkun, T.; Faungnawakij, K. Electrospun Nylon 6.;6/ZIF-8 Nanofiber Membrane for Produced Water Filtration. Water 2019, 11, 2111. [Google Scholar] [CrossRef]
- Yuan, Y.; Zhang, Y. Enhanced biomimic bactericidal surfaces by coating with positively-charged ZIF nano-dagger arrays. Nanomed. Nanotechnol. 2017, 13, 2199–2207. [Google Scholar] [CrossRef] [PubMed]
- Yuan, Y.; Hong, W.; Lu, H.; Zheng, Y.; Ying, J.; Zhang, Y. ZIF nano-dagger coated gauze for antibiotic-free wound dressing. Chem. Commun. 2018, 55, 699–702. [Google Scholar] [CrossRef] [PubMed]
- Low, Z.X.; Yao, J.; Liu, Q.; He, M.; Wang, Z.; Suresh, A.K.; Bellare, J.; Wang, H. Crystal Transformation in Zeolitic-Imidazolate Framework. Cryst. Growth Des. 2014, 14, 6589–6598. [Google Scholar] [CrossRef]
- Rahaman, M.A.; Mousavi, B.; Naz, F.; Verpoort, F. Two-Dimensional Zeolitic Imidazolate Framework ZIF-L: A Promising Catalyst for Polymerization. Catalysts 2022, 12, 521–533. [Google Scholar] [CrossRef]
- Zubair, N.; Akhtar, K. Morphology controlled synthesis of ZnO nanoparticles for in-vitro evaluation of antibacterial activity. Nonferr. Met. Soc. 2020, 30, 1605–1614. [Google Scholar] [CrossRef]
- Tian, S.; Jiang, D.; Pu, J.; Sun, X.; Liu, Z. A new hybrid silicone-based antifouling coating with nanocomposite hydrogel for durable antifouling properties. Chem. Eng. J. 2019, 370, 1–9. [Google Scholar] [CrossRef]
- Mirhosseini, M.; Firouzabadi, F.B. Antibacterial activity of zinc oxide nanoparticle suspensions on food-borne pathogens. Int. J. Dairy Technol. 2013, 66, 291–295. [Google Scholar] [CrossRef]
- Premanathan, M.; Karthikeyan, K.; Jeyasubramanian, K.; Manivannan, G. Selective toxicity of ZnO nanoparticles toward Gram-positive bacteria and cancer cells by apoptosis through lipid peroxidation. Nanomed. Nanotechnol. 2011, 7, 184–192. [Google Scholar] [CrossRef]
- Zhang, K.; Raju, C.; Zhong, W.; Pethe, K.; Chan-Park, M.B. Cationic Glycosylated Block Co-β-peptide Acts on the Cell Wall of Gram-Positive Bacteria as Anti-biofilm Agents. ACS Appl. Bio Mater. 2021, 4, 3749–3761. [Google Scholar] [CrossRef]
- Zhang, X.; Li, H.; Miao, W.; Shen, Q.; Wang, J.; Peng, D.; Liu, J.; Zhang, Y. Vertically Zeolitic Imidazolate Framework-L Coated Mesh with Dagger-like Structure for Oil/Water Separation. AIChE J. 2019, 65, 1. [Google Scholar] [CrossRef]
- Siwach, A.; Verma, P.K. Synthesis and therapeutic potential of imidazole containing compounds. BMC Chem. 2021, 15, 1–69. [Google Scholar] [CrossRef] [PubMed]

Disclaimer/Publisher’s Note: The statements, opinions and data contained in all publications are solely those of the individual author(s) and contributor(s) and not of MDPI and/or the editor(s). MDPI and/or the editor(s) disclaim responsibility for any injury to people or property resulting from any ideas, methods, instructions or products referred to in the content. |
© 2023 by the authors. Licensee MDPI, Basel, Switzerland. This article is an open access article distributed under the terms and conditions of the Creative Commons Attribution (CC BY) license (https://creativecommons.org/licenses/by/4.0/).
Share and Cite
Li, J.; Zhang, Y.; Zhao, H.; Sui, G. Preparation of 2D ZIF-L and Its Antibacterial and Antifouling Properties. Nanomaterials 2023, 13, 202. https://doi.org/10.3390/nano13010202
Li J, Zhang Y, Zhao H, Sui G. Preparation of 2D ZIF-L and Its Antibacterial and Antifouling Properties. Nanomaterials. 2023; 13(1):202. https://doi.org/10.3390/nano13010202
Chicago/Turabian StyleLi, Jingyu, Yang Zhang, Haichao Zhao, and Guoxin Sui. 2023. "Preparation of 2D ZIF-L and Its Antibacterial and Antifouling Properties" Nanomaterials 13, no. 1: 202. https://doi.org/10.3390/nano13010202
APA StyleLi, J., Zhang, Y., Zhao, H., & Sui, G. (2023). Preparation of 2D ZIF-L and Its Antibacterial and Antifouling Properties. Nanomaterials, 13(1), 202. https://doi.org/10.3390/nano13010202

